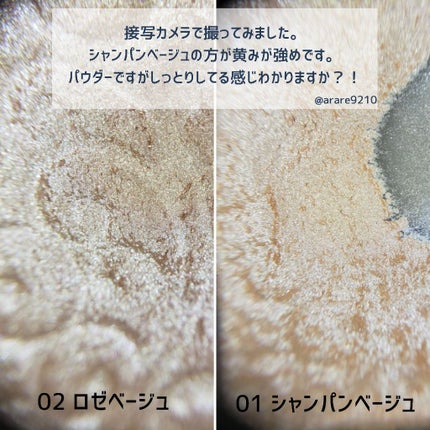
パールグロウハイライト/CEZANNE/パウダーハイライトを使ったクチコミ(4枚目)

高密着のコンシーラー・チーク・ハイライトが1つになったメリハリパレット。服を着替えるように肌も着替えられる。 3種のブレンドパールで、肌のノイズを補正!肌質補正プライマーで、色ムラ、透明感、くすみをカバー チークはどちらのカラーもほんのり血色が良くなる感じ☺️ コンシーラーがめちゃくちゃ便利で、クマを消すオレンジ系、万能なベージュ系の2色が揃ってる✨
もっと見るおすすめアイテムCEZANNE×パウダーハイライト
| 商品画像 | 商品情報 | 参考価格 | 評価 | ランキングIN | 特徴 | 商品リンク |
|---|---|---|---|---|---|---|
CEZANNE パールグロウハイライト | 660円 |
| ハイライト・シェーディングランキング第11位 | 肌のキメを細かく見せてくれる大人気なプチプラハイライト!滲み出るようなツヤ感を演出 | 詳細を見る | |
CEZANNE パールグロウニュアンサー | 660円 |
| ハイライト・シェーディングランキング第19位 | 綺麗な艶が作れます。色もフワッとつくしで、時短メイクにも使えます✨ | 詳細を見る | |
CEZANNE トーンフィルターハイライト | 693円 |
| ハイライト・シェーディングランキング第6位 | 粉質はしっとりしています。 肌馴染みが良くて浮きすぎることなく 使いやすかったです。 | 詳細を見る |
パウダーハイライトランキング
| 商品画像 | 商品情報 | 参考価格 | 評価 | ランキングIN | 特徴 | 商品リンク |
|---|---|---|---|---|---|---|
CEZANNE トーンフィルターハイライト | 693円 |
| ハイライト・シェーディングランキング第6位 | 粉質はしっとりしています。 肌馴染みが良くて浮きすぎることなく 使いやすかったです。 | 詳細を見る | |
クレ・ド・ポー ボーテ ル・レオスールデクラ | 9,350円(編集部調べ) |
| ハイライト・シェーディングランキング第5位 | 細かいラメ感はあるものの発光しているような上品なツヤが印象的! | 詳細を見る | |
muice うるみハイライター | 968円 |
| ハイライト・シェーディングランキング第7位 | そこまでギラギラした感じもないので誰でも使いやすいかなと思います! | 詳細を見る | |
JUDYDOLL JUDYDOLL メリハリマスターパレット | 2,090円 |
| ハイライト・シェーディングランキング第9位 | 陰影や立体感は最近のメイクに必須になっているので、こちらのパレットすごく気に入りました🥰 | 詳細を見る | |
CEZANNE パールグロウハイライト | 660円 |
| ハイライト・シェーディングランキング第11位 | 肌のキメを細かく見せてくれる大人気なプチプラハイライト!滲み出るようなツヤ感を演出 | 詳細を見る | |
fwee フィー グリッツストーンハイライター | 2,090円 |
| ハイライト・シェーディングランキング第15位 | 発色、きらめきともに派手すぎなくてでもしっかり輝いて綺麗! | 詳細を見る | |
excel ドレープド シマーグロウ | 1,760円 |
| ハイライト・シェーディングランキング第16位 | ラメのギラギラしたツヤ感ではなく繊細なパールのツヤ感が本当にキレイ! 肌馴染みが良く浮きにくいハイライトです。 | 詳細を見る | |
M・A・C M·A·C ミネラライズ スキンフィニッシュ | 5,940円 |
| ハイライト・シェーディングランキング第20位 | ほどよいツヤ感で粉っぽさも無く、 あ!付けすぎた?って時もギラギラしないので使いやすい! | 詳細を見る | |
CEZANNE パールグロウニュアンサー | 660円 |
| ハイライト・シェーディングランキング第19位 | 綺麗な艶が作れます。色もフワッとつくしで、時短メイクにも使えます✨ | 詳細を見る | |
SUQQU SUQQU リフレクト ハイライター | 6,600円 |
| ハイライト・シェーディングランキング第25位 | 濡れたようなツヤ感に加えて華やかさと上品さを兼ね備えた輝きがいつものメイクを格上げ! | 詳細を見る |
ズボラアラサー@あられさんの人気クチコミ
※インスタには7枚の画像で紹介しているので、よければインスタもご覧下さい!#オフィスメイクにもオススメ!#ブルベ冬がオススメするグレーブラウンアイシャドウ!#ADDICTION#ザアイシャドウ069FlashBack#lauramercier...
もっと見る
75
7
- 2020.02.04
ロレアルパリカラーリッシュMマットN251パット見た感じ茶色のダークリップですが塗ってみると意外に青みが強いカラーです。ポンポン塗りすれば普段でも使いやすい色になりベタ塗りすれば他を寄せつけない圧倒的な強さの顔面になります。めちゃくちゃマット...
もっと見る
67
25
- 2019.07.10
#アナスイスイブラックルージュS2013,240円(税込)見た目黒すぎ!って思ってダークリップ収集している私としては使命感にかられた1本。塗ってみると意外にピンクパープル系で時間がたつと赤くなります。ティント効果はないらしいですが色持ちかなり...
もっと見る
66
17
- 2019.08.18
【大人気!#セザンヌ#パールグロウハイライトを比較してみた】#favorのプレゼントキャンペーンで02ロゼベージュをいただいたので01シャンパンベージュと比較してみました。01はリアルに愛用しているものなので底見えしている上に汚くてすみません...
もっと見る
61
2
- 2019.09.03
#ベストコスメ2019Part1ベースメイク編です詳細は画像内を参照ください!...
もっと見る
59
4
- 2019.12.27
最近購入したコスメの紹介です♪︎dazzshopスパークリングジェムファンタスティックボルテージ17テクスチャーがプニプニしていて一生触っていたい!肌にのせるとすぐにかわいて密着するので寄れにくくてラメ飛びもしにくいです。私が下手くそなせいで...
もっと見る
57
2
- 2019.07.09
商品詳細情報CEZANNE パールグロウハイライト
- ブランド名
- CEZANNE(セザンヌ)
- ランキングIN
- 全体ランキング年代別ランキングハイライト・シェーディング 10代 第4位ハイライト・シェーディング 20代 第6位ハイライト・シェーディング 30代 第12位ハイライト・シェーディング 40代以上 第12位ハイライト 10代 第4位ハイライト 20代 第6位ハイライト 30代 第12位ハイライト 40代以上 第12位パウダーハイライト 10代 第2位パウダーハイライト 20代 第2位パウダーハイライト 30代 第5位パウダーハイライト 40代以上 第5位肌質別ランキング
- 容量・参考価格
- 2.4g: 660円
- バリエーション
- 01 シャンパンベージュ
- 02 ロゼベージュ
- 03 オーロラミント
- 04 シェルピンク
- 商品説明
- まるで塗るレフ板。濡れツヤ感ハイライト。 高輝度なパールがぎっしり。まるで肌の内側から発光したようなツヤ感を演出。 くすみやクマを光で飛ばして明るさを出し、お顔を立体的に見せます。 美容保湿成分(ヒアルロン酸Na・ラベンダー花エキス・カミツレ花エキス・ローズマリー葉エキス)配合。
- メーカー名
- セザンヌ化粧品
- 発売日
- 2018/9/13(最新発売日: 2021/10/8)
- カテゴリ
- ベースメイク > ハイライト・シェーディング > ハイライト > パウダーハイライト
- 成分
- <01 シャンパンベージュ> トリイソステアリン酸ポリグリセリル-2、トリエチルヘキサノイン、(フッ化/水酸化/酸化)/(Mg/K/ケイ素)、ヘキサ(ヒドロキシステアリン酸/ステアリン酸/ロジン酸)ジペンタエリスリチル、ミリスチン酸亜鉛、(HDI/トリメチロールヘキシルラクトン)クロスポリマー、ペンチレングリコール、ビスジグリセリルポリアシルアジペート-2、フェノキシエタノール、ハイドロゲンジメチコン、メチルパラベン、シリカ、トコフェロール、BG、水、ヒアルロン酸Na、カミツレ花エキス、ラベンダー花エキス、ローズマリー葉エキス、タルク、マイカ、酸化チタン、酸化鉄、酸化スズ、水酸化Al <02 ロゼベージュ> トリイソステアリン酸ポリグリセリル-2、トリエチルヘキサノイン、(フッ化/水酸化/酸化)/(Mg/K/ケイ素)、ヘキサ(ヒドロキシステアリン酸/ステアリン酸/ロジン酸)ジペンタエリスリチル、ミリスチン酸亜鉛、(HDI/トリメチロールヘキシルラクトン)クロスポリマー、ペンチレングリコール、ビスジグリセリルポリアシルアジペート-2、フェノキシエタノール、ハイドロゲンジメチコン、メチルパラベン、シリカ、トコフェロール、BG、水、ヒアルロン酸Na、カミツレ花エキス、ラベンダー花エキス、ローズマリー葉エキス、タルク、マイカ、酸化チタン、酸化鉄、酸化スズ、水酸化Al <03 オーロラミント> トリイソステアリン酸ポリグリセリル-2、トリエチルヘキサノイン、(フッ化/水酸化/酸化)/(Mg/K/ケイ素)、ヘキサ(ヒドロキシステアリン酸/ステアリン酸/ロジン酸)ジペンタエリスリチル、ミリスチン酸亜鉛、(HDI/トリメチロールヘキシルラクトン)クロスポリマー、ペンチレングリコール、ビスジグリセリルポリアシルアジペート-2、フェノキシエタノール、ハイドロゲンジメチコン、メチルパラベン、シリカ、トコフェロール、BG、水、ヒアルロン酸Na、カミツレ花エキス、ラベンダー花エキス、ローズマリー葉エキス、タルク、マイカ、酸化チタン、合成フルオロフロゴパイト、酸化鉄、酸化スズ、グンジョウ、水酸化Al <04 シェルピンク> トリイソステアリン酸ポリグリセリル-2、トリエチルヘキサノイン、(フッ化/水酸化/酸化)/(Mg/K/ケイ素)、ヘキサ(ヒドロキシステアリン酸/ステアリン酸/ロジン酸)ジペンタエリスリチル、ミリスチン酸亜鉛、(HDI/トリメチロールヘキシルラクトン)クロスポリマー、ペンチレングリコール、ビスジグリセリルポリアシルアジペート-2、フェノキシエタノール、ハイドロゲンジメチコン、メチルパラベン、シリカ、トコフェロール、BG、水、ヒアルロン酸Na、カミツレ花エキス、ラベンダー花エキス、ローズマリー葉エキス、タルク、マイカ、酸化チタン、酸化鉄、グンジョウ、酸化スズ、水酸化Al
![LIPS[リップス] - コスメのクチコミ検索アプリ](https://cdn.lipscosme.com/assets/lips_logo_full_2022-bc7b4bc9dd66035bc5696b0d16bc3d38a7be357186656c039e68cc4cf21ae675.png)

コメント